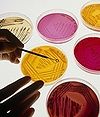

|
|
Материалы 29 июня 2010 г.
 [Гость сайта] – Все зависит от родителей, от воспитания в семье. Если папа и мама смогут направить ребенка в нужное русло – неважно, чем он будет заниматься: спортом или другим каким-то прикладным творчеством, хотя бы лобзиком выпиливать. Главное, чтобы у ребенка было настоящее занятие, тогда на дурное просто не будет времени.  [Интернет-журнал / Книжная закладка] Преподобный Варсонофий Оптинский В наш буйный век духовного растленья / Воочию он миру показал, / Что в людях не погибли высшие стремленья, / И не померк в их сердце идеал.  [Встреча с Православием / Апологетика] Святитель Николай (Велимирович) Вам кажется, что Православная Церковь мало интересуется проблемами мира, и это Вас беспокоит. Как же мало? Кто желал мира больше, чем мученики и исповедники? А мучениками и исповедниками являются все православные народы. Пишу это, не хвалясь и не сожалея, а свидетельствуя известный исторический факт. На Вашем родном языке Вы можете найти книги, в которых содержатся описания многовековых страданий и мук православных народов. Но это лишь небольшая часть той неописуемой глубины страдания, в которую они были погружены столетиями.  [Гость сайта] Вполне возможно, что когда мы начинали нашу деятельность, у горожан могло сложиться некоторое настороженное или предвзятое отношение оттого, что на их глазах возрождается вот эта красота. Наверняка люди задавались вопросом, сколько денег на все это тратится, и могли подумать, что лучше было бы все это поделить и раздать – но это мы уже в нашей истории проходили. Теперь люди увидели, что свои благотворительные проекты мы начали с детей – никакой корысти здесь нет.  [Встреча с Православием / Святые и святыни] Дмитрий Лапа Юный Этельберт, король восточных англов, был вероломно убит мерсийским королем Оффой, к которому приехал сватать его дочь. Тело убитого бросили в болото. Вся Англия была потрясена этим злодеянием. Вскоре тело мученика чудесным образом было обнаружено. Святого Этельберта похоронили в Херефорде, где вскоре воздвигли посвященный ему собор. К раке с мощами святого на протяжении веков стекались паломники со всей страны.  [Встреча с Православием / Православная библиотека] Люди, возгордившиеся частым богообщением, низвергаются в пропасть худшую, чем те, кто не имеет ни какого-либо познания об истинном Боге, ни общения с Ним. Самый очевидный пример сего являет нам народ израильский.  [Встреча с Православием / Православная библиотека] Кондак, глас 4: Богоявлению тезоименитый, святителю Феофане, учении твоими многия люди просветил еси: со Ангелы ныне предстоя Престолу Святыя Троицы, моли непрестанно о всех нас.  [Поместные Православные Церкви / Грузинская / Святые и святыни / Храмы и монастыри] Обзор главных грузинских монастырей, своим основанием восходящих к глубокой древности; указание времени их основания, краткой истории и современного состояния, а также хранящихся в них святынь. Мониторинг СМИ Эту маленькую женщину знают в лицо все милиционеры Московского вокзала в Нижнем Новгороде: три последних года Татьяна Кузнецова варит обеды и возит их сюда – кормит бездомных детей. – Как-то весной шла я мимо вокзала. Вдруг подходит ко мне мальчик и просит: «Тетенька, купите хлебушка!»  Конечно, окружающими тогда все, связанное с Церковью, воспринималось как экзотика. Большинство просто не имело представления о том, что такое Церковь. Помню, меня встретила бывшая коллега, балетмейстер: «Ой, а я же некрещеная — ты меня крестишь?» Ну как я, архивариус, мог ее крестить? Но все же это был конец семидесятых, и люди уже что-то начинали понимать.  Иеромонах Игнатий (Шестаков) Сейчас представители Сербской Церкви убеждают руководство НАТО и КФОР не оставлять охрану сербских святынь, предупреждают о пагубности подобного шага. Возникает впечатление, что трагическая история сербского Косово и Метохии повторяется. В свое время сербским священнослужителям приходилось искать защиты от произвола местных грабителей у турецкого султана. А сейчас на место этого султана, встало НАТО и КФОР и именно в их воле помиловать сербов или оставить на произвол завоевателя. Сергей Худиев Ошибка материалистов в том, что они путают этот методологический натурализм с натурализмом онтологическим — то есть верой в то, что в реальности не существует ничего, кроме материи. Это как если бы мы сказали, что, поскольку химия, в рамках своих методов, ничего не может сказать нам о литературе, литературы не существует. Там, где ученый говорит "в рамках моей дисциплины я этим не занимаюсь" материалист бодро заявляет "этого не существует". Это явная ошибка с точки зрения логики — но это и явная ошибка с точки зрения жизненного выбора. English Edition [News] On June 25, 2010, an archeological expedition comprised of schoolchildren returned from the Monastery of St. Anthony of Siya. The Archangelsk high school students of School No. 9 received a blessing from Archimandrite Triphon last spring to participate in the excavations. This is the third expedition organized jointly between the municipal department of education and School No. 9, within the framework of a municipal experimental project to provide a spiritual and moral education to schoolchildren based upon Orthodox traditions, as the Archangelsk Diocesan press service reports.
|
|